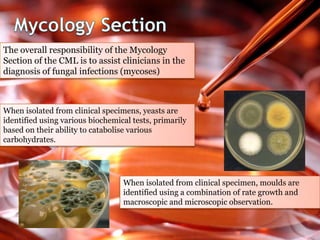
The overall responsibility of the Mycology
Section of the CML is to assist clinicians in the
diagnosis of fungal infections (mycoses)
When isolated from clinical specimens, yeasts are
identified using various biochemical tests, primarily
based on their ability to catabolise various
carbohydrates.
When isolated from clinical specimen, moulds are
identified using a combination of rate growth and
macroscopic and microscopic observation.
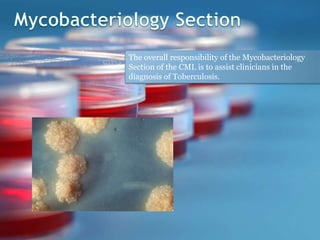
The overall responsibility of the Mycobacteriology
Section of the CML is to assist clinicians in the
diagnosis of Toberculosis.

The document discusses clinical microbiology and the diagnosis of infectious diseases. It covers the following key points in 3 sentences:
Clinical specimens must be properly collected, transported, and processed to accurately diagnose infectious diseases. A variety of specimen types can be used to identify different types of bacterial, fungal, parasitic and viral infections. The clinical microbiology laboratory works to isolate, identify, and test pathogens from specimens to assist clinicians in diagnosing and treating infectious diseases.